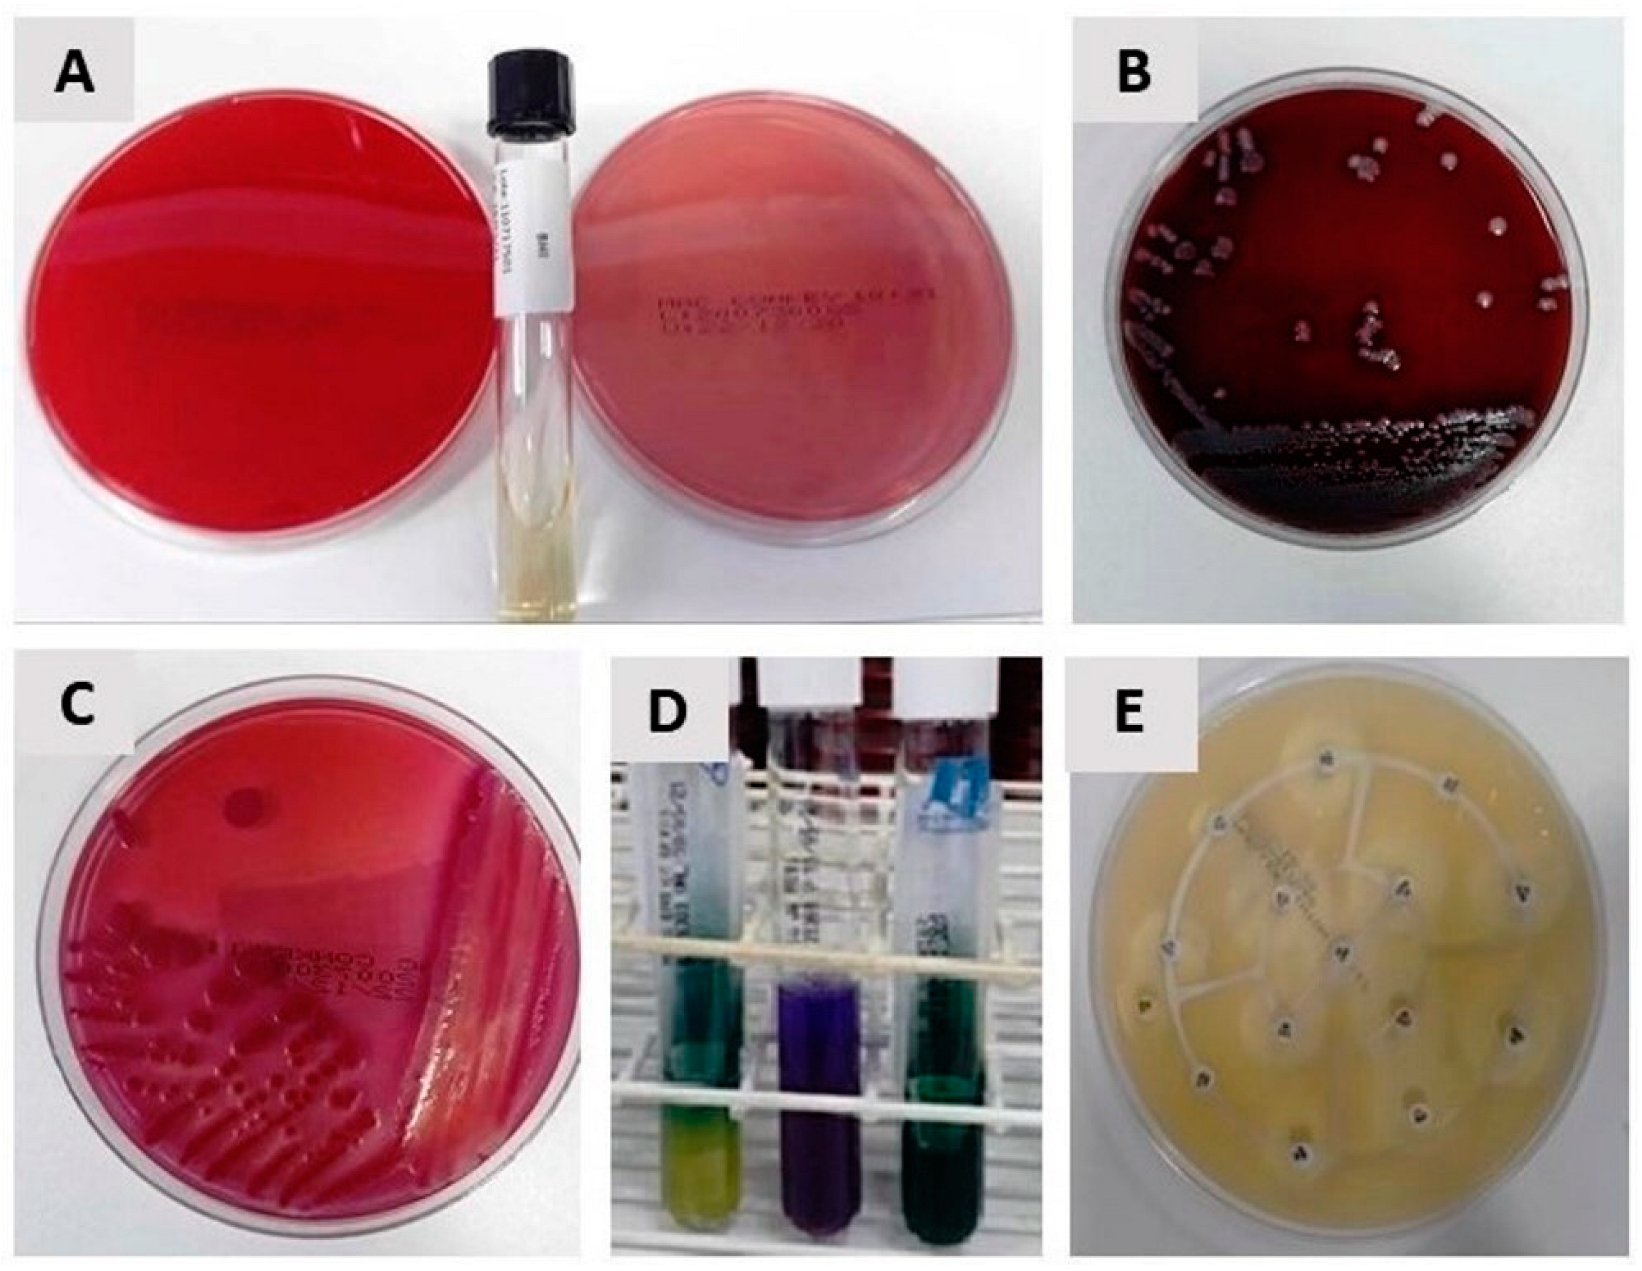
Antibiotics 12 01480 g005

Incidence of Bacteriobilia and the Correlation with Antibioticoprophylaxis in Low-Risk Patients Submitted to Elective Videolaparoscopic Cholecystectomy: A Randomized Clinical Trial
Abstract
:1. Introduction
2. Results
3. Discussion
4. Materials and Methods
4.1. Inclusion Criteria
4.2. Non-Inclusion Criteria
4.3. Experimental Design and Operative Procedures
4.4. Clinical Outcome
4.5. Statistical Analysis
5. Conclusions
Supplementary Materials
Author Contributions
Funding
Institutional Review Board Statement
Informed Consent Statement
Data Availability Statement
Acknowledgments
Conflicts of Interest
References
- De Oliveira, R.S.; da Silva, P.; Queiroz, C.A.S.; Terra-Júnior, J.A.; Crema, E. Prevalence of bacteriobilia in patients undergoing elective colecystectomy. Arq. Bras. Cir. Dig. 2018, 31, 31–33. [Google Scholar] [CrossRef]
- Binda, C.; Gibiino, G.; Coluccio, C.; Sbrancia, M.; Dajti, E.; Sinagra, E.; Capurso, G.; Sambri, V.; Cucchetti, A.; Ercolani, G.; et al. Biliary Diseases from the Microbiome Perspective: How Microorganisms Could Change the Approach to Benign and Malignant Diseases. Microorganisms 2022, 10, 312. [Google Scholar] [CrossRef] [PubMed]
- Tazuma, S.; Unno, M.; Igarashi, Y.; Inui, K.; Uchiyama, K.; Kai, M.; Tsuyuguchi, T.; Maguchi, H.; Mori, T.; Yamaguchi, K.; et al. Evidence-based clinical practice guidelines for cholelithiasis 2016. J. Gastroenterol. 2017, 52, 276–300. [Google Scholar] [CrossRef] [PubMed]
- Farooq, M.O.; Mian, A.; Saeed, B.; Ikram, A.; Qasmi, S.A. Bacteriological patterns and antibiotic sensitivities in calculus cholecystitis. J. Ayub Med. Coll. Abbottabad 2014, 26, 543–547. [Google Scholar] [PubMed]
- Gutt, C.; Schläfer, S.; Lammert, F. The treatment of gallstone disease. Dtsch. Arztebl. Int. 2020, 117, 148–158. [Google Scholar] [CrossRef] [PubMed]
- Littlefield, A.; Lenahan, C. Cholelithiasis: Presentation and Management. J. Midwifery Women’s Health 2019, 64, 289–297. [Google Scholar] [CrossRef]
- Matsui, Y.; Satoi, S.; Kaibori, M.; Toyokawa, H.; Yanagimoto, H.; Matsui, K.; Ishizaki, M.; Kwon, A.H. Antibiotic prophylaxis in laparoscopic cholecystectomy: A randomized controlled trial. PLoS ONE 2014, 9, e106702. [Google Scholar] [CrossRef]
- Pak, M.; Lindseth, G. Risk factors for cholelithiasis. Gastroenterol. Nurs. 2016, 39, 297–309. [Google Scholar] [CrossRef]
- Stinton, L.M.; Shaffer, E.A. Epidemiology of gallbladder disease: Cholelithiasis and cancer. Gut Liver 2012, 6, 172–187. [Google Scholar] [CrossRef]
- Castro, P.M.V.; Akerman, D.; Munhoz, C.B.; Sacramento, I.D.; Mazzurana, M.; Alvarez, G.A. Laparoscopic cholecystectomy versus minilaparotomy in cholelithiasis: Systematic review and meta-analysis. Arq. Bras. Cir. Dig. 2014, 27, 148–153. [Google Scholar] [CrossRef]
- Qureshi, N.A.; Sambyal, V. Laparoscopic Cholecystectomy Outcomes At a Tertiary Level: A Retrospective Study. Int. J. Curr. Res. 2019, 11, 3133–3135. [Google Scholar]
- Sarkut, P.; Kilicturgay, S.; Aktas, H.; Ozen, Y.; Kaya, E. Routine Use of Prophylactic Antibiotics during Laparoscopic Cholecystectomy Does Not Reduce the Risk of Surgical Site Infections. Surg. Infect. Larchmt. 2017, 18, 603–609. [Google Scholar] [CrossRef] [PubMed]
- Grigor’eva, I.N.; Romanova, T.I. Gallstone disease and microbiome. Microorganisms 2020, 8, 835. [Google Scholar] [CrossRef] [PubMed]
- Kim, T.; Park, S.Y.; Kwak, Y.G.; Jung, J.; Kim, M.C.; Choi, S.H.; Yu, S.N.; Hong, H.L.; Kim, Y.K.; Park, S.Y.; et al. Etiology, characteristics, and outcomes of community-onset necrotizing fasciitis in Korea: A multicenter study. PLoS ONE 2019, 14, e0218668. [Google Scholar] [CrossRef]
- Sajid, M.S.; Bovis, J.; Rehman, S.; Singh, K.K. Prophylactic antibiotics at the time of elective cholecystectomy are effective in reducing the post-operative infective complications: A systematic review and meta-analysis. Transl. Gastroenterol. Hepatol. 2018, 3, 22. [Google Scholar] [CrossRef]
- Liang, B.; Dai, M.; Zou, Z. Safety and efficacy of antibiotic prophylaxis in patients undergoing elective laparoscopic cholecystectomy: A systematic review and meta-analysis. J. Gastroenterol. Hepatol. 2016, 31, 921–928. [Google Scholar] [CrossRef]
- Gomez-Ospina, J.C.; Zapata-Copete, J.A.; Bejarano, M.; García-Perdomo, H.A. Antibiotic Prophylaxis in Elective Laparoscopic Cholecystectomy: A Systematic Review and Network Meta-Analysis. J. Gastrointest. Surg. 2018, 22, 1193–1203. [Google Scholar] [CrossRef]
- Valencia-Sánchez, L.; Almendra-Pegueros, R.; Diaz R-Valdez, L.J.; Esmer-Sánchez, D.; Medina, Ú.; Gordillo-Moscoso, A. Dpp-4 as a possible biomarker of inflammation before abdominal surgery for chronic pathology: Our experience with elective cholecystectomy. Medicina 2019, 55, 148. [Google Scholar] [CrossRef]
- Shigemori, T.; Hiasa, A.; Inoue, Y.; Oka, S.; Yasuma, T.; Nishiwaki, R.; Sugimasa, N.; Hamaguchi, T.; Noji, M.; Takeuchi, K.; et al. Acute Calculous Cholecystitis Caused by Streptococcus gallolyticus subspecies pasteurianus: A Case Report. Microorganisms 2022, 10, 1929. [Google Scholar] [CrossRef]
- Francesca, V.; Francesco, F.; Eugenio, C.; Carmelo, M. Management of Cholelithiasis in Cirrhotic Patients. J. Pers. Med. 2022, 12, 2060. [Google Scholar] [CrossRef]
- Zdanowicz, K.; Daniluk, J.; Lebensztejn, D.M.; Daniluk, U. The Etiology of Cholelithiasis in Children and Adolescents—A Literature Review. Int. J. Mol. Sci. 2022, 23, 3376. [Google Scholar] [CrossRef] [PubMed]
- Frade, S.; Carrelha, S.; Monteiro, N.; Moniz, L.; Viegas, H. Missed gallstones in the abdominal wall: Complication of a laparoscopic cholecystectomy. Pan Afr. Med. J. 2020, 37, 381. [Google Scholar] [CrossRef] [PubMed]
- Al Salamah, S.M. Outcome of laparoscopic cholecystectomy in acute cholecystitis. J. Coll. Physicians Surg. Pakistan 2005, 15, 400–403. [Google Scholar]
- Strohäker, J.; Bareiß, S.; Nadalin, S.; Königsrainer, A.; Ladurner, R.; Meier, A. The prevalence and clinical significance of anaerobic bacteria in major liver resection. Antibiotics 2021, 10, 139. [Google Scholar] [CrossRef] [PubMed]
- Surat, G.; Meyer-Sautter, P.; Rüsch, J.; Braun-Feldweg, J.; Markus, C.K.; Germer, C.T.; Lock, J.F. Cefazolin Might Be Adequate for Perioperative Antibiotic Prophylaxis in Intra-Abdominal Infections without Sepsis: A Quality Improvement Study. Antibiotics 2022, 11, 501. [Google Scholar] [CrossRef] [PubMed]
- Granel-Villach, L.; Gil-Fortuño, M.; Fortea-Sanchis, C.; Gamón-Giner, R.L.; Martínez-Ramos, D.; Escrig-Sos, V.J. Factors that influence bile fluid microbiology in cholecystectomized patients. Rev. Gastroenterol. Mex. 2020, 85, 257–263. [Google Scholar] [CrossRef]
- Gotthardt, D.N.; Weiss, K.H.; Rupp, C.; Bode, K.; Eckerle, I.; Rudolph, G.; Bergemann, J.; Kloeters-Plachky, P.; Chahoud, F.; Büchler, M.W.; et al. Bacteriobilia and fungibilia are associated with outcome in patients with endoscopic treatment of biliary complications after liver transplantation. Endoscopy 2013, 45, 890–896. [Google Scholar] [CrossRef]
- Linassi, F.; Obert, D.P.; Maran, E.; Tellaroli, P.; Kreuzer, M.; Sanders, R.D.; Carron, M. Implicit memory and anesthesia: A systematic review and meta-analysis. Life 2021, 11, 850. [Google Scholar] [CrossRef]
- Hsieh, C.Y.; Poon, Y.Y.; Ke, T.Y.; Chiang, M.H.; Li, Y.Y.; Tsai, P.N.; Wu, S.C. Postoperative vomiting following laparoscopic cholecystectomy is associated with intraoperative fluid administration: A retrospective cohort study. Int. J. Environ. Res. Public Health 2021, 18, 5305. [Google Scholar] [CrossRef]
- Mayhew, D.; Mendonca, V.; Murthy, B.V.S. A review of ASA physical status–historical perspectives and modern developments. Anaesthesia 2019, 74, 373–379. [Google Scholar] [CrossRef]
- Kastanis, G.; Topalidou, A.; Alpantaki, K.; Rosiadis, M.; Balalis, K. Is the ASA Score in Geriatric Hip Fractures a Predictive Factor for Complications and Readmission? Scientifica 2016, 2016, 7096245. [Google Scholar] [CrossRef]
- Jaafar, G.; Darkahi, B.; Lindhagen, L.; Persson, G.; Sandblom, G. Disparities in the regional, hospital and individual levels of antibiotic use in gallstone surgery in Sweden. BMC Surg. 2017, 17, 128. [Google Scholar] [CrossRef] [PubMed]
- Cristina, M.L.; Spagnolo, A.M.; Giribone, L.; Demartini, A.; Sartini, M. Epidemiology and prevention of healthcare-associated infections in geriatric patients: A narrative review. Int. J. Environ. Res. Public Health 2021, 18, 5333. [Google Scholar] [CrossRef] [PubMed]
- Nair, H.K.R.; Tatavilis, N.; Pospíšilová, I.; Kučerová, J.; Cremers, N.A.J. Medical-grade honey kills antibiotic-resistant bacteria and prevents amputation in diabetics with infected ulcers: A prospective case series. Antibiotics 2020, 9, 529. [Google Scholar] [CrossRef] [PubMed]
- Yaqin, H.; Sultan, G. The results of culture of gallbladder, bile and gall-stones. J. Pak. Med. Assoc. 1978, 28, 31–32. [Google Scholar] [PubMed]
- Al Harbi, M.; Osoba, A.O.; Mowallad, A.; Al-Ahmadi, K. Tract microflora in Saudi patients with cholelithiasis. Trop. Med. Int. Health 2001, 6, 570–574. [Google Scholar] [CrossRef]
- Sattar, I.; Aziz, A.; Rasul, S.; Mehmood, Z.; Khan, A. Frequency on infection in cholelithiasis. J. Coll. Physicians Surg. Pakistan 2007, 17, 48–50. [Google Scholar]
- Suh, S.W.; Choi, Y.S.; Choi, S.H.; Do, J.H.; Oh, H.C.; Kim, H.J.; Lee, S.E. Antibiotic selection based on microbiology and resistance profiles of bile from gallbladder of patients with acute cholecystitis. Sci. Rep. 2021, 11, 2969. [Google Scholar] [CrossRef]
- Thapa, S.B.; Bajracharya, K.; Kher, Y.R.; Pant, S.S.; Gurung, S.; Pudasaini, R. Aerobic Bacteria Associated with Symptomatic Gallstone Disease and their Antimicrobial Susceptibility in Western Nepal. J. Lumbini Med. Coll. 2016, 4, 50. [Google Scholar] [CrossRef]
- de Azevedo e Sousa Munhoz, M.; Pomini, K.T.; de Guzzi Plepis, A.M.; da Conceição Amaro Martins, V.; Machado, E.G.; de Moraes, R.; Cunha, F.B.; Santos, A.R.; Cardoso, G.B.C.; Duarte, M.A.H.; et al. Elastin-derived scaffolding associated or not with bone morphogenetic protein (BMP) or hydroxyapatite (HA) in the repair process of metaphyseal bone defects. PLoS ONE 2020, 15, e0231112. [Google Scholar] [CrossRef]
- Yang, J.; Gong, S.; Lu, T.; Tian, H.; Jing, W.; Liu, Y.; Si, M.; Han, C.; Yang, K.; Guo, T. Reduction of risk of infection during elective laparoscopic cholecystectomy using prophylactic antibiotics: A systematic review and meta-analysis. Surg. Endosc. 2021, 35, 6397–6412. [Google Scholar] [CrossRef] [PubMed]
- Ely, S.; Rothenberg, K.A.; Beattie, G.; Gologorsky, R.C.; Huyser, M.R.; Chang, C.K. Modern Elective Laparoscopic Cholecystectomy Carries Extremely Low Postoperative Infection Risk. J. Surg. Res. 2020, 246, 506–511. [Google Scholar] [CrossRef] [PubMed]
- Shindholimath, V.V.; Seenu, V.; Parshad, R.; Chaudhry, R.; Kumar, A. Factors influencing wound infection following laparoscopic cholecystectomy. Trop. Gastroenterol. 2003, 24, 90–92. [Google Scholar]
- Uchiyama, K.; Kawai, M.; Onishi, H.; Tani, M.; Kinoshita, H.; Ueno, M.; Yamaue, H. Preoperative Antimicrobial Administration for Prevention of Postoperative Infection in Patients with Laparoscopic Cholecystectomy. Dig. Dis. Sci. 2003, 48, 1955–1959. [Google Scholar] [CrossRef] [PubMed]
- Vieira Cunha Rudge, M.; Nagib Atallah, Á.; Carlos Peraçoli, J.; Da Rocha Tristão, A.; Mendonça Neto, M. Randomized controlled trial on prevention of postcesarean infection using penicillin and cephalothin in Brazil. Acta Obstet. Gynecol. Scand. 2006, 85, 945–948. [Google Scholar] [CrossRef]
- Rodrigues, W.F.; Miguel, C.B.; Nogueira, A.P.O.; Ueira-Vieira, C.; Paulino, T.D.P.; Soares, S.D.C.; De Resende, E.A.M.R.; Lazo-Chica, J.E.; Araújo, M.C.; Oliveira, C.J. Antibiotic resistance of bacteria involved in urinary infections in Brazil: A cross-sectional and retrospective study. Int. J. Environ. Res. Public Health 2016, 13, 918. [Google Scholar] [CrossRef]

| Variables | Categories | Group | Total | p Value | ||
|---|---|---|---|---|---|---|
| Experimental A | Control B | |||||
| Gender | Male | n (%) | 3 (15.0) | 3 (15.0) | 6 (15.0) | 0.669 |
| Female | n (%) | 17 (85.0) | 17 (85.0) | 34 (85.0) | ||
| ASA | II | n (%) | 9 (45.0) | 13 (65.0) | 22 (55.0) | 0.341 |
| I | n (%) | 11 (55.0) | 7 (35.0) | 18 (45.0) | ||
| Culture | Positive | n (%) | 2 (10.0) | 9 (45.0) | 11 (27.5) | 0.031 * |
| Negative | n (%) | 18 (90.0) | 11 (55.0) | 29 (72.5) | ||
| Hypertension | Yes | n (%) | 6 (30.0) | 5 (25.0) | 11 (27.5) | 0.500 |
| No | n (%) | 14 (70.0) | 15 (75.0) | 29 (72.5) | ||
| Diabetes | Yes | n (%) | 3 (15.0) | 4 (20.0) | 7 (17.5) | 0.500 |
| No | n (%) | 17 (85.0) | 16 (80.0) | 33 (82.5) | ||
| Hypothyroidism | Yes | n (%) | 3 (15.0) | 6 (30.0) | 9 (22.5) | 0.451 |
| No | n (%) | 17 (85.0) | 14 (70.0) | 31 (77.5) | ||
| Smoking | Yes | n (%) | 4 (20.0) | 4 (20.0) | 8 (20.0) | 0.653 |
| No | n (%) | 16 (80.0) | 16 (80.0) | 32 (80.0) | ||
| Obesity | Yes | n (%) | 2 (10.0) | 0 (0.0) | 2 (5.0) | 0.487 |
| No | n (%) | 18 (90.0) | 20 (100.0) | 38 (95.0) | ||
| Complications | Yes | n (%) | 11 (55.0) | 11 (55.0) | 22 (55.0) | 0.999 |
| No | n (%) | 9 (45.0) | 9 (45.0) | 18 (45.0) | ||
| Culture | X2 | Odds | CI 95% (Odds) | |||||
|---|---|---|---|---|---|---|---|---|
| Positive | Negative | p Value | Inferior | Superior | ||||
| ASA | II | n | 10 | 12 | 0.006 * | 14.1 † | 1.59 | 125.8 |
| % | 90.9% | 41.4% | ||||||
| I | n | 1 | 17 | |||||
| % | 9.1% | 58.6% | ||||||
| Antibiotic | Yes | n | 2 | 18 | 0.014 * | 0.13 † | 0.02 | 0.74 |
| % | 18.2% | 62.1% | ||||||
| No | n | 9 | 11 | |||||
| % | 81.8% | 37.9% | ||||||
| Gender | Male | n | 1 | 5 | 0.524 | 0.48 | 0.05 | 4.64 |
| % | 9.1% | 17.2% | ||||||
| Female | n | 10 | 24 | |||||
| % | 90.9% | 82.8% | ||||||
| Hypertension | Yes | n | 4 | 7 | 0.445 | 0.17 | 0.40 | 8.00 |
| % | 36.4% | 24.1% | ||||||
| No | n | 7 | 22 | |||||
| % | 63.6% | 75.9% | ||||||
| Diabetes | Yes | n | 2 | 5 | 0.945 | 1.06 | 0.17 | 6.51 |
| % | 18.2% | 17.2% | ||||||
| No | n | 9 | 24 | |||||
| % | 81.8% | 82.8% | ||||||
| Hypothyroidism | Yes | n | 4 | 5 | 0.202 | 2.74 | 0.57 | 13.00 |
| % | 36.4% | 17.2% | ||||||
| No | n | 7 | 24 | |||||
| % | 63.6% | 82.8% | ||||||
| Smoking | Yes | n | 4 | 4 | 0.116 | 3.57 | 0.70 | 18.00 |
| % | 36.4% | 13.8% | ||||||
| No | n | 7 | 25 | |||||
| % | 63.6% | 86.2% | ||||||
| Obesity | Yes | n | 0 | 2 | 0.378 | - | - | - |
| % | 0.0% | 6.9% | ||||||
| No | n | 11 | 27 | |||||
| % | 100.0% | 93.1% | ||||||
| Complications | Yes | n | 13 | 9 | 0.570 | 1.44 | 0.41 | 5.06 |
| % | 59.1% | 50% | ||||||
| No | n | 9 | 9 | |||||
| % | 40.9% | 50% | ||||||
| Variables | B | Odds | IC 95% Odds | p Value | Model | |||
|---|---|---|---|---|---|---|---|---|
| Dependent | Independent | Inferior | Superior | p Value | R2 | |||
| Culture (positive) | ASA | 2.59 | 13.30 | 1.38 | 128.33 | 0.025 * | 0.001 † | 0.426 |
| Antibiotic | −1.92 | 0.15 | 0.02 | 0.92 | 0.041 * | |||
| Constant | 0.72 | 2.06 | 0.723 | |||||
| Variables | Categories | Complication Rate | X2 | ||||
|---|---|---|---|---|---|---|---|
| No (Score 1) | Mild (Score 2) | Moderate (Score 3) | Severe (Score 4) | p Value | |||
| ASA | II | n (%) | 13 (59.1) | 3 (33.3) | 2 (50.0) | 4 (80.0) | 0.769 |
| I | n (%) | 9 (40.9) | 6 (66.7) | 2 (50.0) | 1 (20.0) | ||
| Group | Experimental A | n (%) | 11 (50.0) | 6 (66.7) | 2 (50.0) | 1 (20.0) | 0.374 |
| Control B | n (%) | 11 (50.0) | 3 (33.3) | 2 (50.0) | 4 (80.0) | ||
| Culture | Positive | n (%) | 7 (31.8) | 1 (11.1) | 1 (25.0) | 2 (40.0) | 0.947 |
| Negative | n (%) | 15 (68.2) | 8 (88.9) | 3 (75.0) | 3 (60.0) | ||
| Group (Antibiotic) | Culture | Total | X2 | Effect Size | Power | ||
|---|---|---|---|---|---|---|---|
| Positive | Negative | p Value | |||||
| Experimental A | n (%) | 2 (5.0) | 18 (45.0) | 20 (50.0) | 0.014 | 0.57 | 89.00% |
| Control B | n (%) | 9 (22.5) | 11 (27.5) | 20 (50.0) | |||
| Total | n (%) | 11 (27.5) | 29 (72.5) | 40 (100.0) | |||
Disclaimer/Publisher’s Note: The statements, opinions and data contained in all publications are solely those of the individual author(s) and contributor(s) and not of MDPI and/or the editor(s). MDPI and/or the editor(s) disclaim responsibility for any injury to people or property resulting from any ideas, methods, instructions or products referred to in the content. |
© 2023 by the authors. Licensee MDPI, Basel, Switzerland. This article is an open access article distributed under the terms and conditions of the Creative Commons Attribution (CC BY) license (https://creativecommons.org/licenses/by/4.0/).
Share and Cite
Pagani, M.A., Junior; Dolfini, P.M.; Trazzi, B.F.d.M.; Dolfini, M.I.M.; da Silva, W.S.; Chagas, E.F.B.; Reis, C.H.B.; Pilon, J.P.G.; Pagani, B.T.; Strasser, R.T.; et al. Incidence of Bacteriobilia and the Correlation with Antibioticoprophylaxis in Low-Risk Patients Submitted to Elective Videolaparoscopic Cholecystectomy: A Randomized Clinical Trial. Antibiotics 2023, 12, 1480. https://doi.org/10.3390/antibiotics12101480
Pagani MA Junior, Dolfini PM, Trazzi BFdM, Dolfini MIM, da Silva WS, Chagas EFB, Reis CHB, Pilon JPG, Pagani BT, Strasser RT, et al. Incidence of Bacteriobilia and the Correlation with Antibioticoprophylaxis in Low-Risk Patients Submitted to Elective Videolaparoscopic Cholecystectomy: A Randomized Clinical Trial. Antibiotics. 2023; 12(10):1480. https://doi.org/10.3390/antibiotics12101480
Chicago/Turabian StylePagani, Marcos Alberto, Junior, Pedro Meira Dolfini, Beatriz Flávia de Moraes Trazzi, Maria Ines Meira Dolfini, William Saranholi da Silva, Eduardo Federighi Baisi Chagas, Carlos Henrique Bertoni Reis, João Paulo Galletti Pilon, Bruna Trazzi Pagani, Rodrigo Tavore Strasser, and et al. 2023. "Incidence of Bacteriobilia and the Correlation with Antibioticoprophylaxis in Low-Risk Patients Submitted to Elective Videolaparoscopic Cholecystectomy: A Randomized Clinical Trial" Antibiotics 12, no. 10: 1480. https://doi.org/10.3390/antibiotics12101480
APA StylePagani, M. A., Junior, Dolfini, P. M., Trazzi, B. F. d. M., Dolfini, M. I. M., da Silva, W. S., Chagas, E. F. B., Reis, C. H. B., Pilon, J. P. G., Pagani, B. T., Strasser, R. T., Mendes, C. G., Vernaschi, F. T., Buchaim, D. V., & Buchaim, R. L. (2023). Incidence of Bacteriobilia and the Correlation with Antibioticoprophylaxis in Low-Risk Patients Submitted to Elective Videolaparoscopic Cholecystectomy: A Randomized Clinical Trial. Antibiotics, 12(10), 1480. https://doi.org/10.3390/antibiotics12101480








